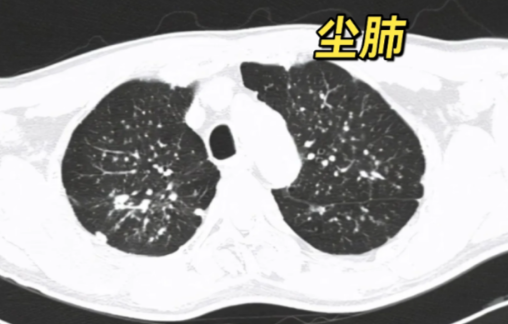
image.png

尘肺与矽肺是由于长期吸入含游离二氧化硅的粉尘所引起的肺部疾病。科学合理的饮食虽不能直接治疗疾病,但能够有效增强患者体质、缓解部分症状,是辅助康复的重要一环。以下是为患者整理的饮食与生活建议,供参考:

一、推荐食物类别
01优质蛋白类:
瘦肉:如牛肉、鸡胸肉、鱼肉,提供易吸收的蛋白质,帮助维持肌肉功能和体力;
豆制品与奶类:豆腐、豆浆、牛奶、酸奶等,富含蛋白质和钙质,有助于组织修复与营养补充。
02富含维生素的食物:
果蔬选择:苹果、猕猴桃、柑橘、菠菜、芹菜等富含维生素C,有助提高免疫力、抗氧化;
动物肝脏:适量摄入动物肝脏可补充维生素A,有助于呼吸道黏膜修复,缓解咳嗽。
03传统清肺食物:
黑木耳:被认为具有一定的吸附作用,有助于清理呼吸道;
猪血:其成分可与某些尘埃及有害物质结合,促进排出。

二、饮食禁忌需注意
忌辛辣刺激:如辣椒、胡椒、生姜、大蒜等,可能刺激呼吸道,加剧咳嗽;
控制糖与油脂:高糖甜点、油炸食品易生痰,妨碍呼吸道通畅;
避免生冷饮食:如冰品、冷饮等,可能刺激气道和消化系统,引发不适;
减少高盐摄入:咸菜、腌制品等过咸食物增加身体代谢负担,应尽量少吃。
三、日常生活管理建议
远离粉尘环境:彻底脱离高粉尘工作与生活场所,避免进一步吸入刺激物;
改善居室空气质量:经常通风,避免使用空气清新剂、香水等化学喷雾,远离厨房油烟;
加强个人防护:若无法完全避免粉尘环境,应正确佩戴防护口罩;
保持适度运动:如散步、太极拳和深呼吸训练,有助提升肺功能,但要避免剧烈运动;
注重休息与防寒:保证充足睡眠,注意保暖,预防呼吸道感染;
定期复查与遵医嘱:持续进行胸部影像学和肺功能检查,按医生建议接受规范治疗。
饮食与生活习惯的调整,是支持尘肺/矽肺患者稳定病情、提升生活质量的重要方式。请务必结合专业医疗建议,进行系统性的健康管理。





